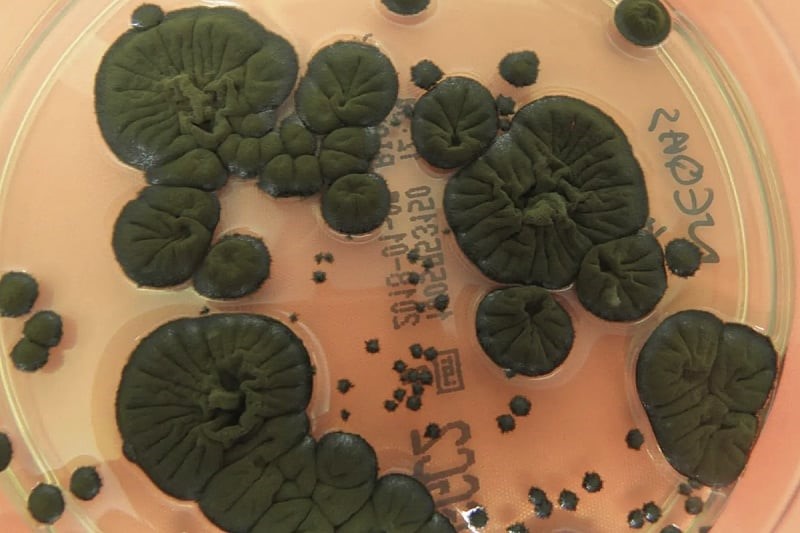

Истраживачи су открили да она на месту нуклеарне катастрофе у Чернобиљу преживљава хранећи се смртоносним зрачењем.
Чернобиљска црна гљива, која претвара нуклеарно зрачење у енергију, могла би помоћи астронаутима Истраживачи су открили да она на месту нуклеарне катастрофе преживљава хранећи се смртоносним зрачењем. Kатастрофа се догодила 26. априла 1986. године, када је рутински сиогурнсни тест у реактору 4 прерастао у најгору нуклеарну несрећу на свету, која је узрокована грешкама у дизајну и раду. Да би се ублажило тровање зрачењем, успостављена је зона искључења од 30 километара, која држи људе даље од опасности. Упркос ризику, неки истраживачи су спровели студије о томе како зрачење утиче на околно окружење.
На пример, 1997. је украјинска миколошкиња Нели Жданова открила црну плесан која колонизује високо радиоактивне рушевине нуклеарне електране растући по зидовима, плафонима, чак и унутар зграде реактора. Истраживање је показало да гљиве привлачи јонизујуће зрачење. Ово изванредно откриће да живот може напредовати и расти у присуству зрачења довело је у питање устаљена тумачења о отпорности живота, а такође је указало на потенцијал за коришћење ове плесни за чишћење радиоактивних места и заштиту астронаута од космичког зрачења у свемиру.
Јонизујуће зрачење, које обично уништава ДНK и ћелије, изгледало је као храњива твар за ове отпорне гљиве. Чини се да је тајна заправо меланин. Исти пигмент који људима даје различите тонове коже и штити од ултраљубичастих (UV) зрака налази се у ћелијским зидовима чернобиљских гљива. Почетне претпоставке сугерисале су да меланин штити црну плесан, међутим студија нуклеарног научника из 2007. године открила је кључни налаз. Меланизоване гљиве расле су 10 посто брже када су биле изложене радиоактивном цезијуму, што упућује да су користиле зрачење за метаболичку енергију. Овај процес назван је радио-синтеза.
„Енергија јонизујућег зрачења је око милион пута већа од енергије беле светлости која се користи у фотосинтези. Дакле, потребан је прилично снажан претварач енергије, и то је оно што мислимо да меланин може учинити – претворити јонизујуће зрачење у употребљиве нивое енергије”, рекла је за BBC нуклеарна научница Екатерина Дадачова. Даља истраживања су открила да не показују све меланизоване гљиве ово понашање, а једна студија чак није пронашла разлику у расту код тестираних узорака када су изложени зрачењу. Заинтригирана међународна научзаједница послала је примерке Cladosporium sphaerospermum, истог соја пронађеног у Чернобиљу, на Међународну свемирску станицу (ISS). Оно што се догодило учврстило је космички потенцијал плесни. Суочене с интензивним космичким зрачењем, гљиве су напредовале, показујући стопу раста 1,21 пута већу од контролних узорака на тлу. Занимљиво је да је овај експеримент такође показао потенцијал плесни као заштитне баријере. Kако су се гљиве развијале, штитиле су од значајне количине зрачења у поређењу с контролним подручјима.
Из ових експерименат, стручњаци сугеришу да уочене радио-протективне користи плесни можда нису искључиво последица меланина, већ могуће и других биолошких компоненти попут воде. Галактичко космичко зрачење, олуја брзих набијених протона из експлодирајућих звезда, представља највећу опасност за астронауте који се упуштају у путовање иван Земљине заштитне атмосфере. Стандардна решења заштите, попут тешких метала, скупа су и тешка за лансирање. Овај чернобиљски калуп нуди једноставну, биолошку алтернативу.
Астробиолошкиња из NASA Лин Џеј Ротшилд замишља микоархитектуру, станишта узгајена од гљива на Месецу или Марсу. Ови живи зидови не би били самоструктурни, они би били саморегенеришући радијацијски штитови, што би драстично смањило трошкове лансирања. Након што су колонизовале токсично место попут Чернобиља гљиве би у коначници могле заштитити астронауте у блиској будућности.
(Kликс)